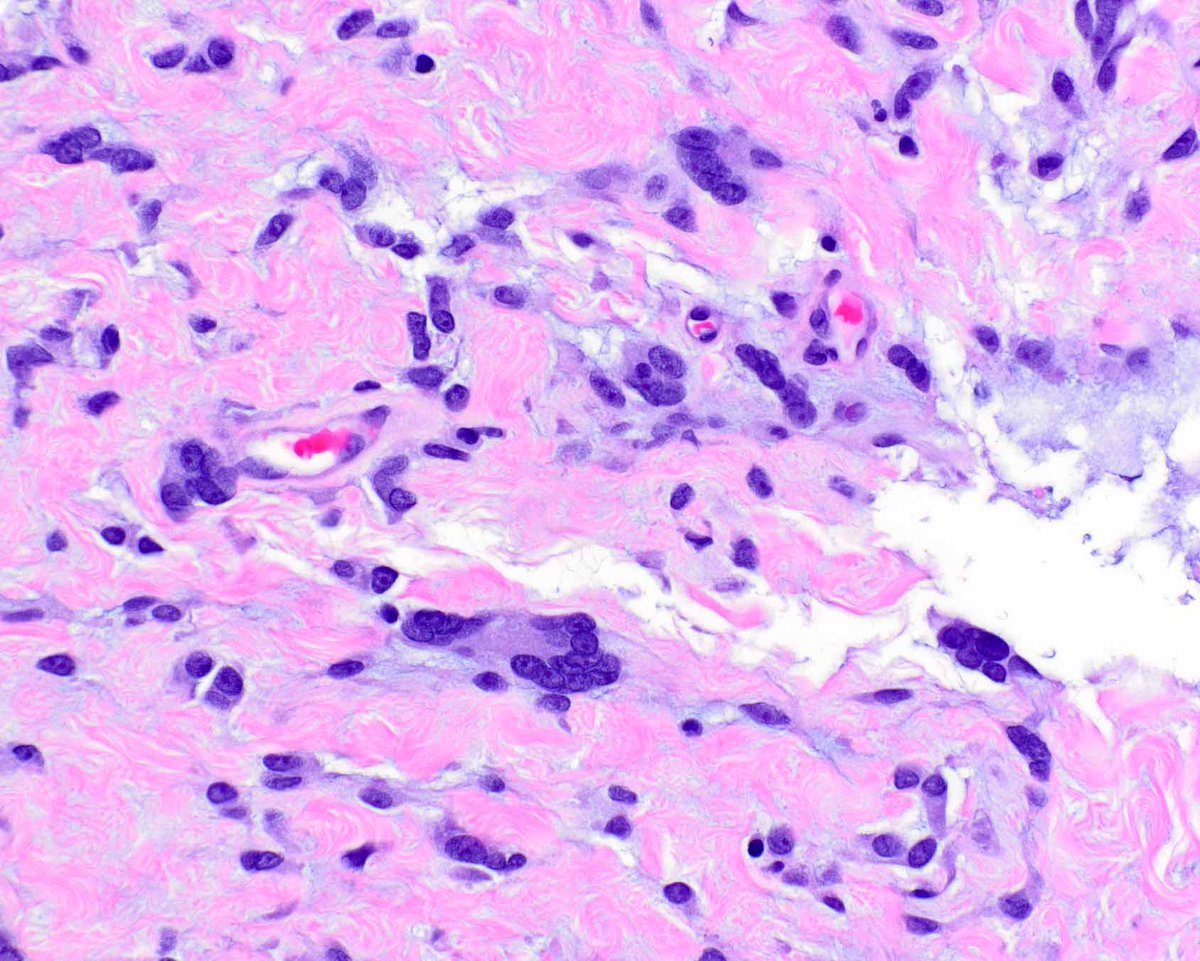
LizMontgomeryMD's tweet image. This is an example of a dermatofibrosarcoma protuberans (DFSP) arising in association with a giant cell fibroblastoma, the latter considered a forme fruste DFSP. #UMiamiPath @ModernPathology @science_press

Irene Rodriguez O.
@irepath
Medico Cirujano-ULA MD Anatomopatologo Hospital Vargas de Caracas Felow en Patologia Pediatrica. HJM De Los Rios. Mastologo SVM. Miembro Directivo SVAP
You might like
La Medicina ha perdido el respeto por los viejos maestros. El culto vulgar a la novedad, la fascinación por la tecnología irrelevante, el desprecio por la palabra como fuente de conocimiento, han hecho el trabajo sucio. El libro de Henry Marsh es un antídoto contra esos venenos.

Mucocele like lesions-Breast Mucocele-like lesions without atypia on core biopsy have an upgrade rate to carcinoma of approximately 5%. The majority are referred for surgical excision, particularly if there are residual calcifications Pic below: Atypical ductal hyperplasia,…

A dreadful carcinosarcoma (metaplastic carcinoma) of breast featuring poorly differentiated glands and sarcomatoid (metaplastic) component. IHC showed a triple negative carcinoma. Associated with poor prognosis. #pathology #breastpath #metaplastic_carcinoma




Indeed. We are fortunate. The @IACytology could not be in better hands🔝🔝💯 @sza_jhcyto #ProudMIAC
Congratulations To Prof. Syed Ali @sza_jhcyto Who Takes Over The Mantle Of Leadership As President, IAC @IACytology

Papilla does not mean carcinoma in #thyroid #pathology Nodules with cystic degeneration can show beautiful ones 😁 Nuclear features are mandatory. #medicine #path #endocrine



Capsular invasion -Mushrooming Thyroid carcinoma #PathTwitter #pathresidents

This is an example of a dermatofibrosarcoma protuberans (DFSP) arising in association with a giant cell fibroblastoma, the latter considered a forme fruste DFSP. #UMiamiPath @ModernPathology @science_press

We are offering a virtual weekend GI and Liver course! Please join us. processing.miami.edu/Processed/Week…

¡Éxito de la Anatomía Patológica en el #2MIR25! 🔬🤩. Participación directa e indirecta en 23 preguntas (10%). Ayuda a dar visibilidad a esta especialidad tan importante y tan bonita 😍. @CTOMedicinaES @SEAP_IAP. Vamos a desglosar las preguntas 📝:
#EverydayGYN Algorithm to screen uterine smooth muscle tumors for FH-deficiency and HLRCC FH-d morphology -Alveolar pattern edema -Staghorn blood vessels -Chain-like growth of tumor cells -Macronucleoli surrounded by halo -Cytoplasmic eosinophilic globules Dr. Turashvili #CCSP24…

✨And it's a wrap! The #EScoP course for Nephropathology is now concluded! We would like to thank all participants who joined us in Basel and the Faculty for their energy to provide this course! 🗺️Next #EScoP stop is Nuremberg! #pathology #education #PathTwitter

📣 It's that time again! We're hosting a #CytoChat all about the #BethesdaSystem for Reporting Thyroid Cytopathology, led by our EIC @bfaquin & Associate Editors @DianaEstherossi @Sinchita_Roy @MichiyaNishino 🔬 Join us & other leading experts on June 18 at 11am EDT! #CytoPath

Ayer vi la película. Para quien sepa poco sobre el personaje, puede resultar interesante. A quien lo conozca, la asombrosa ausencia de rigor histórico, político y militar puede parecerle, como a mí, un disparate indigno del hombre que dirigió la obra maestra "Los duelistas".

#URGENTE Piloto de Tareck El Aissami y Samark López se declara culpable en NY. Michols Orsini Quintero asumió su culpabilidad por haber violado las sanciones impuestas por el gobierno de #EEUU. Enfrenta una condena de 5 años de prisión #Venezuela maibortpetit.info/2023/09/piloto…

🚨 ¡Atención! se presentó balacera en el centro comercial Unicentro ► bit.ly/42BiMll Noticia en desarrollo...

Sal con gente que simplifica lo complejo, no con los que complejizan lo simple.
Please Share! @cytopathology is doing a survey of Pathologist-Performed USFNA! Goal is to: Gather data from cytopath US-FNA services Identify pertinent elements in US-FNA cytology reports Recommend a unified reporting format SURVEY HERE: uwmadison.co1.qualtrics.com/jfe/form/SV_6J…

Her Majesty Queen Elizabeth II

Different Sites and Angles of Injections 💉 .
United States Trends
- 1. #OlandriaxRahulMishra N/A
- 2. Tom Homan N/A
- 3. Roval N/A
- 4. #MondayMotivation N/A
- 5. Ran Gvili N/A
- 6. Good Monday N/A
- 7. Amex N/A
- 8. #MaduroCiliaHeroes N/A
- 9. Scheelhaase N/A
- 10. #PMSSuperBowlSZN N/A
- 11. Chris Madel N/A
- 12. Udinski N/A
- 13. Kanye West N/A
- 14. #MondayVibes N/A
- 15. Browns HC N/A
- 16. Ghana N/A
- 17. Cramer N/A
- 18. $CRWV N/A
- 19. Signal N/A
- 20. Cava N/A
Something went wrong.
Something went wrong.
















































































































































